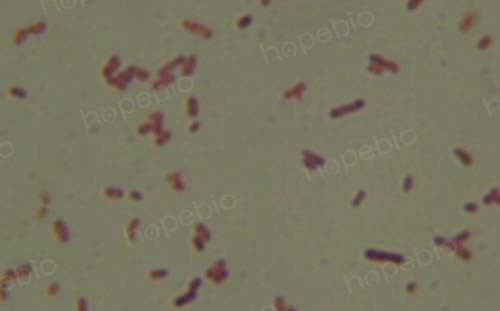
大肠埃希菌培养,大肠埃希菌70%正常吗
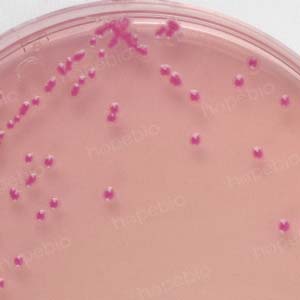
大肠埃希菌培养,大肠埃希菌70%正常吗
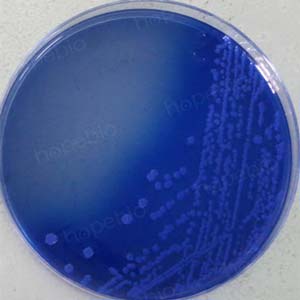
大肠埃希菌培养,大肠埃希菌70%正常吗

一、标准 《GB4789.36-2016 食品安全国家标准 食品微生物学检验 大肠埃希氏菌O157:H7/NM检验》第一法:常规培养法 二、大肠埃希氏菌O157:H7/NM简介 大肠埃希氏菌是动物肠道中正常菌群之一,极少数可引起人类疾病,具有致病性的大肠埃希氏菌主要由六种致泻大肠埃希氏菌(DEC)组成:肠道致病性大肠埃希氏菌(EPEC)、肠道侵袭性大肠埃希氏菌(EIEC)、产肠毒素大肠埃希氏菌(ETEC)、产志贺毒素大肠埃希氏菌(STEC)、肠道出血性大肠埃希氏菌(EHEC)、肠道集聚性大肠埃希氏菌(EAEC)。大肠埃希氏菌O157属于肠道出血性大肠埃希氏菌(EHEC),O157:H7为常见血清型代表菌株,O157:NM为无动力菌株。 三、检验流程

3.1 增菌 以无菌操作取检样25g(或25mL)加入到含有225mL mEC+n肉汤的均质袋中,在拍击式均质器上连续均质1 min~2 min;或放入盛有225 mL mEC+n肉汤的均质杯中,8000r/min~10000r/min均质1min~2min。 36 ℃±1℃培养18h~24h。3.2 分离 取增菌后的mEC+n肉汤,划线接种于CT-SMAC平板和大肠埃希氏菌O157显色琼脂平板上,36℃±1℃培养18h~24h,观察菌落形态。(1)改良山梨醇麦康凯琼脂(CT-SMAC) 大肠埃希氏菌O157通常不发酵或迟缓发酵山梨醇,而大肠埃希氏菌则可以发酵山梨醇产酸,因此常用山梨醇麦康凯琼脂或改良山梨醇麦康凯琼脂分离大肠埃希氏菌O157。大肠埃希氏菌O157在CT-SMAC平板上由于不能分解山梨醇产酸,通常为圆形无色菌落,中心显灰褐色,而能发酵山梨醇产酸的大肠埃希氏菌、沙门氏菌等在CT-SMAC上菌落显粉红色或桃红色,菌落周围有时可见沉淀环。
|
|
CT-SMAC平板上的大肠埃希氏菌O157(左)和普通大肠埃希氏菌(右)
(2)O157菌显色培养基 O157菌显色培养基利用特异性酶底物法原理,大肠埃希氏菌O157在显色培养基上呈亮红色菌落,而大肠埃希氏菌、沙门氏菌、大肠菌群等在显色培养基上呈蓝色。
|
|
O157菌显色培养基——大肠埃希氏菌O157(左)、大肠埃希氏菌(右)
3.3 初步生化试验 在CT-SMAC和大肠埃希氏菌O157显色琼脂平板上分别挑取5个~10个可疑菌落,分别接种TSI琼脂,同时接种 MUG-LST 肉汤,并用大肠埃希氏菌株(ATCC25922或等效标准菌株)做阳性对照和大肠埃希氏菌O157:H7(NCTC12900或等效标准菌株)做阴性对照,于36℃±1℃培养18h~24h。必要时进行氧化酶试验和革兰氏染色。 注:挑取可疑菌落接种三糖铁琼脂和LST-MUG后,可同时划线至营养琼脂平板,以备后续做血清学试验和生化试验使用。 (1)三糖铁琼脂(TSI)试验 挑取可疑菌落在三糖铁斜面“之”字形划线并穿刺接种后,置于36±1℃培养18-24h。大肠埃希氏菌O157与大肠埃希氏菌在三糖铁琼脂上反应相同,均可发酵乳糖和葡萄糖产酸产气,不产硫化氢,现象为斜面和底层均为黄色(A/A),底层无黑色出现(H2S阴性),琼脂可见断层(产气)。若斜面出现红色(K/A或K/K),或底层出现黑色(H2S阳性),均可排除大肠埃希氏菌O157。

TSI试验现象
TSI使用注意事项:(1)配制时需加热煮沸至琼脂完全溶解,分装至试管。若琼脂未完全溶解就进行分装,易出现灭菌后培养基不凝固问题;(2)培养过程中斜面需要与空气中的氧气发生反应,因此必须使用透气性良好的试管塞或半开盖培养,不可密闭培养。 (2)LST-MUG荧光试验 挑取可疑菌落接种至LST-MUG培养基中(需同时接种MUG阳性的大肠埃希氏菌和MUG阴性的大肠埃希氏菌O157做对照),置于36±1℃培养18-24h。培养结束后,在黑暗中使用365nm波长紫外灯照射,观察有无荧光。大肠埃希氏菌O157不能分解MUG产荧光,而大肠埃希氏菌可分解MUG产荧光。

MUG试验(左为大肠埃希氏菌有荧光,右为大肠埃希氏菌O157无荧光)
注:在标准附录A培养基的配制方法中,要求配制LST-MUG需使用带小倒管的试管,但在检验过程中却并未要求观察是否产气。大肠埃希氏菌O157和大肠埃希氏菌都是可以发酵乳糖产气的,因此在试验中还可以看到小倒管中有气体产生(标准未提及)。 (3)革兰氏染色 大肠埃希氏菌O157为革兰氏阴性杆菌(红色杆菌)。
(4)氧化酶试验 纸片法:使用少量无菌生理盐水润湿氧化酶试纸,用塑料接种环挑取可疑菌落涂抹至氧化酶试纸,阳性结果通常在30秒内出现深蓝色(若使用的氧化酶试剂为N,N'-二甲基对苯二胺盐酸盐,阳性结果为紫红色),2分钟内不变色即为氧化酶阴性。大肠埃希氏菌O157氧化酶试验为阴性,不出现深蓝色。

氧化酶试验(左为大肠埃希氏菌O157阴性,右为铜绿假单胞菌阳性)
注意事项:挑取菌落时应使用塑料接种环,玻璃棒或铂金接种环,不可使用铁制品,否则可能出现假阳性反应。 3.4 鉴定(1)血清学试验 在营养琼脂平板上挑取分离纯化的菌落,用O157和H7诊断血清或 O157乳胶凝集试剂作玻片凝集试验。对于H7因子血清不凝集者,应穿刺接种半固体琼脂,检查动力,经连续传代3次,动力试验均阴性,确定为无动力株。 注:需同时使用O157血清和H7血清做凝集试验,若均凝集,则为大肠埃希氏菌O157:H7菌株;若O157血清凝集而H7血清不凝集,需穿刺接种半固体琼脂检查动力,若连续传代3次动力试验均为阴性,则为大肠埃希氏菌O157:NM菌株;若传代过程出现动力阳性,可再次使用H7血清做凝集试验,检查是否为O157:H7菌株。 (2)生化试验 大肠埃希氏菌O157生化反应结果:靛基质阳性,山梨醇发酵为阴性或迟缓阳性,甲基红(MR)阳性,V-P阴性,赖氨酸脱羧酶阳性,鸟氨酸脱羧酶阳性,西蒙氏柠檬酸盐阴性,纤维二糖阴性,棉子糖阳性,O157:H7菌株动力阳性,O157:NM菌株动力阴性。 注:1.靛基质、甲基红、VP试验均需培养结束后滴加相应试剂观察结果,靛基质和甲基红试验滴加试剂后应立即观察结果,VP试验滴加试剂后应继续培养0.5-4h观察结果;2.赖氨酸脱羧酶、鸟氨酸脱羧酶试验需同时做氨基酸脱羧酶对照管,接种后并覆盖无菌液体石蜡,当对照管变黄,试验管变紫时为氨基酸脱羧酶阳性反应,若对照管与试验管均为黄色,则为氨基酸脱羧酶阴性反应,若对照管未变黄色,可能试验菌为非发酵型细菌,不能直接判断氨基酸脱羧酶反应的阴阳性(O157菌为发酵菌,对照管必变黄);3.山梨醇迟缓发酵型细菌,培养24h内通常观察不到阳性结果,需延长培养2-7天后可见阳性结果。
大肠埃希氏菌O157:H7生化鉴定结果
3.5 毒力基因测定(选做) 样品中检出大肠埃希氏菌 O157:H7或 O157:NM 时,如需要进一步检测 Vero细胞毒素基因的存在,可通过接种 Vero细胞或 HeLa细胞,观察细胞病变进行判定;也可使用基因探针检测或聚合酶链反应(PCR)方法进行志贺毒素基因(stx1、stx2)、eae、hly 等基因的检测。3.6 结果报告 综合生化和血清学试验结果,报告25g(或25mL)样品中检出或未检出大肠埃希氏菌 O157:H7或大肠埃希氏菌 O157:NM。 注:出具结果报告时,要写明检出的O157菌的具体血清型是H7或NM。
注:本文属海博生物原创,未经允许不得转载。